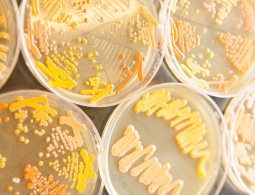

Ученые поняли, как работает «фермент бессмертия»
О поисках бессмертия или хотя бы продления жизни написан не один роман, снят не один фильм и проведена масса научных работ. Но дело в том, что так называемый фермент бессмертия найден уже достаточно давно, а вот разгадать его секрет и приблизиться к желанной многими вечной жизни удалось сравнительно...
Генетическая флешка: как записать книгу на ДНК
Рост объема цифровой информации побуждает ученых искать более компактные способы ее записи и хранения. А что может быть компактнее ДНК? РИА Новости вместе с экспертом выяснило, как закодировать слова нуклеотидами и сколько данных вмещает одна молекула.Основания-кодыДНК пр...
В Ростове ученые создали устройство для быстрой передачи данных через стены
Ростовские ученые первыми в России создали устройство для скоростной передачи гигабайтов информации сквозь стены, сообщили РИА Новости в Фонде перспективных исследований (ФПИ)."В Ростовском-на-Дону НИИ радиосвязи в рамках проекта ФПИ впервые в нашей стране созд...
Коты мартовские: когда гормоны ударяют в голову
Первого марта мы отмечаем сразу два праздника — наступление весны и День кошек. И это не случайно, ведь кошки, как утверждают ученые, именно в марте начинают активно подыскивать себе пару. Почему так происходит, читайте в материале РИА Новости."Гормональн...
На Марсе может быть жизнь. Засушливый климат не помеха.
В поисках неизученных, гипотетически обитаемых планетарных объектов астрономы обращают пристальное внимание на один определяющий факт – присутствует или отсутствует на конкретном астрономическом теле уловимые следы воды в одном из трёх своих состояний. Это стало профессиональной привычкой. На...
Медики рассказали, как защитить будущего ребенка от аллергии
Медики советуют беременным женщинам употреблять больше рыбьего жира и пробиотиков для того, чтобы снизить риск развития аллергии у их будущих детей, говорится в статье, опубликованной в журнале PLoS Medicine."Несмотря на то, что различные формы пищевой алл...
Ученые назвали новые опасные последствия депрессии
Ученые из канадского Центра наркологии и психического здоровья при Университете Торонто установили, что долгая депрессия может привести к изменениям в мозге. Результаты исследования опубликованы в журнале The Lancet Psychiatry.В исследовании приняли участие 25 челов...
Кожа, как известно, наружный покров тела, имеющий в достаточной степени высокую способность к самовосстановлению и самовоспроизводству, если говорить об эпидермисе. Но при опасных повреждениях (обморожение, ожоги, ранения подкожной клетчатки), коже требуется профессиональный медицинский уход, в том...
Как рацион влияет на эмоциональное состояние
Небезисветсный рекламный слоган регулярно возвещает с экранов телевизоров о том, что голод ни тётка, да и в целом - ты сам на себя не похож без шоколадного батонщике в желудке. Но на эмотивный статус человека гораздо больше пустоты в животе влияют продукты питания. Этот факт недавно установили учёны...
Роскосмос объявил о создании специального спутника для поиска полезных ископаемых
Поиск и освоение недр с целью получение большего количества ресурсов - задача, стоящая на экономической повестке дня каждого современного государства. Фундаментальные принципы геологической разведки подразумевают крупные финансовые, производственные и трудовые издержки, при отсутствии гарантии обесп...
Что будет, если на Земле станет на 2°C теплее?
Если мир станет теплее на два градуса Цельсия, мы обречены. Чтобы предотвратить это, ООН подписала Парижское соглашение, международный договор, согласно которому подписанты будут пытаться поддерживать среднюю мировую температуру «на 2°C ниже доиндустриального уровня». Доиндустриальны...
В будущем мы не будем редактировать геном. Мы будем создавать новый
С тех пор, как шумеры впервые захотели выпить пива, а было это тысячи лет назад, Homo sapiens обзавелись тесными отношениями с Sacharomyces cerevisae, одноклеточными грибами, более известными как пивные дрожжи. Благодаря ферментации люди смогли использовать этот микроскопический вид для своих целей....